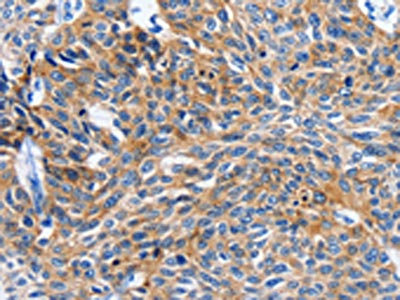

ITGAL Antibody
-
中文名稱:ITGAL兔多克隆抗體
-
貨號:CSB-PA932598
-
規格:¥1100
-
圖片:
-
The image on the left is immunohistochemistry of paraffin-embedded Human esophagus cancer tissue using CSB-PA932598(ITGAL Antibody) at dilution 1/20, on the right is treated with synthetic peptide. (Original magnification: ×200)
-
The image on the left is immunohistochemistry of paraffin-embedded Human liver cancer tissue using CSB-PA932598(ITGAL Antibody) at dilution 1/20, on the right is treated with synthetic peptide. (Original magnification: ×200)
-
-
其他:
產品詳情
-
Uniprot No.:
-
基因名:
-
別名:Antigen CD11A (p180); lymphocyte function associated antigen 1; alpha polypeptide antibody; CD11 antigen-like family member A antibody; CD11a antibody; CD18 antibody; CR3 antibody; Integrin alpha-L antibody; Integrin beta 2 antibody; Integrin gene promoter antibody; ITAL_HUMAN antibody; Itgal antibody; ITGAM antibody; ITGB2 antibody; LAD antibody; Leukocyte adhesion glycoprotein LFA-1 alpha chain antibody; Leukocyte function-associated molecule 1 alpha chain antibody; LFA 1 alpha antibody; LFA 1 antibody; LFA-1A antibody; LFA1 antibody; LFA1A antibody; Lymphocyte function associated antigen 1 antibody; MAC1 antibody; MFI7 antibody; MO1A antibody
-
宿主:Rabbit
-
反應種屬:Human
-
免疫原:Synthetic peptide of Human ITGAL
-
免疫原種屬:Homo sapiens (Human)
-
標記方式:Non-conjugated
-
抗體亞型:IgG
-
純化方式:Antigen affinity purification
-
濃度:It differs from different batches. Please contact us to confirm it.
-
保存緩沖液:-20°C, pH7.4 PBS, 0.05% NaN3, 40% Glycerol
-
產品提供形式:Liquid
-
應用范圍:ELISA,IHC
-
推薦稀釋比:
Application Recommended Dilution ELISA 1:1000-1:2000 IHC 1:15-1:50 -
Protocols:
-
儲存條件:Upon receipt, store at -20°C or -80°C. Avoid repeated freeze.
-
貨期:Basically, we can dispatch the products out in 1-3 working days after receiving your orders. Delivery time maybe differs from different purchasing way or location, please kindly consult your local distributors for specific delivery time.
-
用途:For Research Use Only. Not for use in diagnostic or therapeutic procedures.
相關產品
靶點詳情
-
功能:Integrin ITGAL/ITGB2 is a receptor for ICAM1, ICAM2, ICAM3 and ICAM4. Integrin ITGAL/ITGB2 is a receptor for F11R. Integin ITGAL/ITGB2 is a receptor for the secreted form of ubiquitin-like protein ISG15; the interaction is mediated by ITGAL. Involved in a variety of immune phenomena including leukocyte-endothelial cell interaction, cytotoxic T-cell mediated killing, and antibody dependent killing by granulocytes and monocytes. Contributes to natural killer cell cytotoxicity. Involved in leukocyte adhesion and transmigration of leukocytes including T-cells and neutrophils. Required for generation of common lymphoid progenitor cells in bone marrow, indicating a role in lymphopoiesis. Integrin ITGAL/ITGB2 in association with ICAM3, contributes to apoptotic neutrophil phagocytosis by macrophages.
-
基因功能參考文獻:
- LFA-1 cross-linking recruits and activates FAK1 and PYK2 to phosphorylate LAT selectively on a single Y-171 site that binds to the GRB2-SKAP1 complex and limits dwell times of T-cells with dendritic cells PMID: 28699640
- Data show that integrin alphaLbeta2 (LFA-1) is oriented relative to actin retrograde flow. PMID: 29229906
- These results demonstrated that histone demethylase JMJD3 regulates CD11a expression in lupus T cells by affecting the H3K27me3 levels in the ITGAL (CD11a) promoter region, and JMJD3 might thereby serve as a potential therapeutic target for SLE. PMID: 28430662
- Data show a nadir of CD11a expression at 2 years of natalizumab treatment in multiple sclerosis, at the peak of incidence of progressive multifocal leukoencephalopathy, indirectly suggesting that a lack of these molecules may play a role in the onset of PML in NTZ-treated patients. PMID: 24258149
- Extracellular ISG15 signals cytokine secretion through the LFA-1 integrin receptor (CD11a/CD18) in natural killer cells. PMID: 29100055
- Suggest possible role for lymphocyte CD11a in the pathogenesis immune thrombocytopenia. PMID: 26884833
- The alphaI domain, tethered through its N-linker and a disulfide to a stable beta-ribbon pillar near the center of the platform, can undergo pivoting and tilting motions that appear buffered by N-glycan decorations that differ between alphaL and alphaX subunits. PMID: 26936951
- beta2 integrins-mediated chemosensory adhesion and migration of polymorphonuclear leukocytes on the vascular graft surface, bacterial cellulose. PMID: 25231265
- Data show that interleukin-18 was involved in the eosinophil-mediated death of colon carcinoma cells via upregulation of CD11a/CD18 and ICAM-1 adhesion molecules. PMID: 26216891
- shear-induced CD11/CD18 cleavage is phenotypic of neutrophilic cells, including those derived from HL60 cells PMID: 24276331
- Data show that leucocyte function-associated antigen-1 (integrin alphaLbeta2), DNAX accessory molecule-1 (DNAM-1) or tumour necrosis factor-related apoptosis-inducing ligand (TRAIL) enhance osteoclast survival when co-cultured with activated NK cells. PMID: 25684021
- LFA-1 function is regulated through conformational changes that include the modulation of ligand binding affinity and molecular extension. PMID: 25378583
- the blocking of LFA-1/ICAM-1 interaction resulted in a significant increase in the percentage of IL-17(+) T cells expanded in nonclassical monocyte/T-cell cocultures PMID: 25678252
- Studied signaling mechanisms of Lymphocyte function-associated antigen-1 (LFA-1) using NMR analysis of the dynamics of the LFA-1 I-domain. PMID: 25147050
- CD11a, CD11c, and CD18 gene polymorphisms and susceptibility to Behcet's disease in Koreans. PMID: 25155097
- ITGAL is overexpressed in systemic lupus erythematosus CD4+ T cells, but expression is not linked to the typical clinical and serological parameters associated with the disease. PMID: 24238281
- there was reduced expression of CD11a, CD11b, and CD18 in trisomy 12 cases with NOTCH1 mutations compared with wild type. PMID: 24829201
- We conclude, that deficiency of CD11a expression should be added to the diagnostic criteria of AML-M7, classical DS-AML and TMD. PMID: 23450818
- genetic polymorphism is associated with atopic disease and relevant allergic indices PMID: 23726040
- Distribution of integrin beta(2) is also markedly altered in M. tuberculosis-infected DCs. A corresponding reduction in the alphaL (CD11a) and alphaM (CD11b) subunits that associate with integrin beta(2) was also observed. PMID: 23981064
- Allele frequencies were determined in the blood donor population as follows: 0.318 for HNA-1a, 0.668 for HNA-1b, 0.014 for HNA-1c, 0.768 for HNA-3a, 0.232 for HNA-3b, 0.882 for HNA-4a, 0.118 for HNA-4b, 0.736 for HNA-5a and 0.264 for HNA-5b. PMID: 23398146
- The results of this study suggest that polyamine-induced suppression of LFA-1 expression occurs via enhanced methylation of ITGAL. PMID: 23418509
- Binding kinetics differences between LFA-1 and macrophage-1 antigen (Mac-1) are quantified and insight provided into their distinct functions in the neutrophil inflammatory cascade. PMID: 23514737
- common and rare variants in FTO, SERPINA12, and ITGAL predict PON1 acti PMID: 23160181
- Flow-based adhesion assay showed that engagement of CD103 or LFA-1, together with TCR, enhances the strength of the T-cell/target cell interaction PMID: 23188505
- Cytotoxicity of CD56(bright) NK cells towards autologous activated CD4+ T cells is mediated through NKG2D, LFA-1 and TRAIL and dampened via CD94/NKG2A PMID: 22384114
- Binding of LtxA to LFA-1 resulted in the internalization of both LtxA and LFA-1, with LtxA localizing specifically to the lysosomal compartment. PMID: 22467872
- This work demonstrates an intricate coupling between conformation and lateral diffusion of LFA-1 and further underscores the crucial role of mobility for the onset of LFA-1 mediated leukocyte adhesion. PMID: 22411821
- DNA hypermethylation at the CD11a locus contributes to the lowered expression of CD11a in biliary atresia CD4+ T cells. PMID: 22206678
- CD70 and CD11a facilitate the survival of T and B lymphocytes and indirectly enhance the destruction of platelets in immune thrombocytopenia. PMID: 21541792
- Regulator of G protein signaling (RGS) represses Galpha-dependent signaling during chemokine-activated integrin alphaLbeta2- and alpha4beta1- dependent T cell adhesion. PMID: 21705617
- N-terminal myr-tagged SKAP1 for membrane binding facilitated constitutive RapL membrane and Rap1 binding and effectively substituted for PI3K and TCR ligation in the activation of LFA-1 in T cells. PMID: 21669874
- hyperketonemia can induce monocyte adhesion to endothelial cells and it is mediated via increased ICAM-1 expression in endothelial cells and increased expression and affinity of LFA-1 in monocytes PMID: 21540444
- We show that sequential cleavage of C-terminal amino acids from the beta(2) cytoplasmic tail of LFA-1, by cathepsin X, enhances binding of the adaptor protein talin to LFA-1 and triggers formation of the latter's high-affinity form PMID: 21454358
- Bordetella pertussis adenylate cyclase toxin binds to T cells via LFA-1 and induces its disengagement from the immune synapse PMID: 21576384
- Studies indicate that transformation of LFA1 from a bent, resting form to an extended conformation is essential for T cell migration and the formation of an immunological synapse. PMID: 21597477
- LFA-1-induced stabilization of ARE-containing mRNAs in T cells is dependent on HuR, and occurs through the Vav-1, Rac1/2, MKK3 and p38MAPK signaling cascade PMID: 21206905
- RFX1 recruits SUV39H1 to the promoter regions of the CD11a and CD70 genes in CD4(+) T cells, thereby regulating local H3K9 tri-methylation levels. PMID: 21192791
- 2B4-mediated increase in natural killer (NK) cell adhesion to tumor targets is actin- and LFA-1-dependent, demonstrating that inside-out signaling is very fast and its effects can be detected as early as 90 seconds after cell contact. PMID: 21270395
- Findings support the idea that calpain is involved in the turnover of LFA-1 adhesions at the rear of the cell. PMID: 21152086
- the high-affinity state of LFA-1 on T cells is critical to induce targeted movements of both ICAM-1 and MHC class II to the immunological synapse on APCs. PMID: 20681010
- Decreased chemotactic response and downregulated expression of CD11a in an experimental model of depression could be an important mechanisms to induce impaired immune responses in experimental and clinical depression. PMID: 20516718
- Case Report: Possible acceleration of regression by antibiotic treatment in benign cephalic histiocytosis with infiltration of CD11a/CD11c+ macrophages. PMID: 20574620
- Human neutrophil rolling on E- or P-selectin induces the extended alpha(L)beta(2) integrin conformation through signaling triggered by PSGL-1 engagement. PMID: 20445017
- T helper (Th)17 cells adhere to mesenchymal stem cells through the joined involvement of CCR6 and CD11a/CD18 and their respective ligands, interactions that induce a regulatory phenotype in fully polarized tissue-infiltrating Th17 cells. PMID: 20511548
- These results provide an example of the stabilizing effect of polar interactions within the low dielectric environment of the membrane interior and demonstrate its importance in the regulation of alpha L beta 2 function. PMID: 20338181
- Activation-induced conformational changes in the I domain region of lymphocyte function-associated antigen 1 PMID: 11792712
- important role for the integrin LFA-1 and the microtubular cytoskeleton in the Ca(2)(+)-mediated activation of PYK2 in T-lymphocytes PMID: 11867690
- regulation of LFA-1 activation and neutrophil arrest on intercellular adhesion molecule 1 in shear flow PMID: 11929876
- cd11a may play an important role in pathogenic process(in COPD) PMID: 11953106
顯示更多
收起更多
-
亞細胞定位:Cell membrane; Single-pass type I membrane protein.
-
蛋白家族:Integrin alpha chain family
-
組織特異性:Leukocytes.
-
數據庫鏈接:
Most popular with customers
-
-
Phospho-YAP1 (S127) Recombinant Monoclonal Antibody
Applications: ELISA, WB, IHC
Species Reactivity: Human
-
-
-
-
-
-